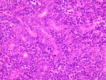
Figure 2

A malignant eccrine spiradenoma of the scalp
- PMID: 24842352
- PMCID: PMC4039856
- DOI: 10.1136/bcr-2013-202524
A malignant eccrine spiradenoma of the scalp
Abstract
Malignant eccrine spiradenoma (MES) is an extremely rare but aggressive tumour, resulting in high mortality. We report the first case in the UK of metastatic MES on the scalp of a 37-year-old man who initially presented with a raised nodular mass which had grown rapidly over a few months. Excision biopsy of the lesion was performed and histology confirmed MES with evidence of cytological atypia and necrosis. A further wide local excision of the lesion with a 1 cm surgical margin was performed and full clearance was achieved. At 10-month follow-up another similar lesion had developed close to the previously excised area. A CT scan demonstrated metastatic lesions in the lungs, liver and pelvis, and subsequently chemotherapy was initiated. Although MES is uncommon, it has a high propensity to metastasise, therefore prompt identification, treatment and close follow-up of these tumours is essential.
2014 BMJ Publishing Group Ltd.
Figures
References
-
- Marenda SA, Otto RA. Adnexal carcinomas of the skin. Otolaryngol Clin North Am 1993;26:87–116 - PubMed
-
- Beekley AC, Brown TA, Porter C. Malignant eccrine spiradenoma: a previously unreported presentation and review of the literature. Am Surg 1999;65:236–40 - PubMed
-
- Dabska M. Malignant transformation of eccrine spiradenoma. Pol Med J 1972;11:388–96 - PubMed
-
- Seyhan T, Borman H, Bal N. Malignant eccrine spiradenoma of the scalp. J Craniofac Surg 2008;19:1608–12 - PubMed
-
- Russ BW, Meffert J, Bernert R. Spiradenocarcinoma of the scalp. Cutis 2002;69:455–8 - PubMed
Publication types
MeSH terms
LinkOut - more resources
Full Text Sources
Other Literature Sources
Miscellaneous